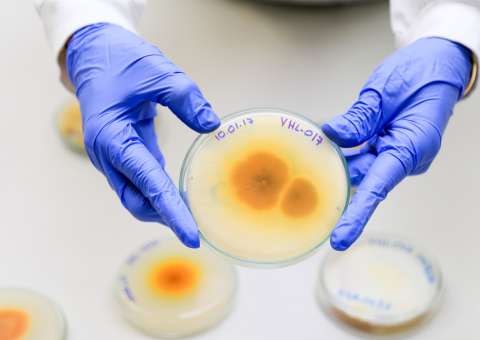
Fungos presente na Amazônia podem combater Aedes Aegypti

A inscrição prévia está sendo feita no setor de comunicação da Unidade
Na próxima quinta-feira (30), a partir das 16h, o ônibus da Fundação Hospitalar de Hematologia e Hemoterapia do Amazonas (Hemoam), estará em frente a Faculdade Maurício de Nassau aguardando por doadores de sangue. A ação faz parte Campanha do Trote Legal, que esse ano tem como tema a doação de sangue.
Doar sangue é a forma mais simples para salvar vidas, e a instituição convida a todos, seja ou não estudante da Nassau, para no dia 30 de março fazer a sua contribuição. Os cadastros antecipados já podem ser feitos no setor de comunicação da Unidade. Aos doadores, serão disponibilizados certificados de 10 horas complementares.
Lembrando que para doar, o voluntário deve apresentar documento original com foto recente, que permita a identificação do candidato, emitido por órgão oficial (Carteira de Identidade, Cartão de Identidade de Profissional Liberal, Carteira de Trabalho e Previdência Social); estar em boas condições de saúde; pesar no mínimo 50kg; estar descansado (ter dormido pelo menos seis horas nas últimas 24 horas); estar alimentado (evitar alimentação gordurosa nas quatro horas que antecedem a doação).
Não podem participar as pessoas que já tiveram hepatite ou malária, quem recebeu transfusão de sangue nos últimos 12 meses, portadores de doenças sexualmente transmissíveis, como HIV e Hepatite B e C, mulheres grávidas ou amamentando e quem teve febre nos últimos 30 dias.
A Faculdade Maurício de Nassau está localizada na Av. Djalma Batista, nº 377, Chapada. Para mais informações, entrar em contato pelo número (92) 3236 3960.

Aviso